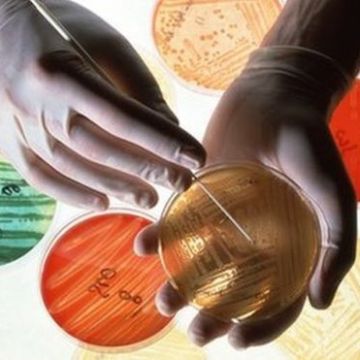

The Biodiversity Project
The Biodiversity Project
Category Projects
 The Biodiversity Project
The Biodiversity Project
 The Ocean Acidification Project
The Ocean Acidification Project
 The Sustainability Project
The Sustainability Project
 The Oil Spill Project
The Oil Spill Project
The Antibiotic Resistance Project
The Antibiotic Resistance Project
 The Malaria Project
The Malaria Project
 The Water Project
The Water Project
 The Elephant Tusk Project
The Elephant Tusk Project
 The Diabetes Project
The Diabetes Project
